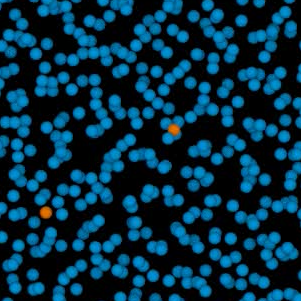
Dense Plasma OCP

Dense Matter Theory Simulation Video
The following videos highlight simulation work conducted by the Dense Matter Theory team. While each represents a detailed scientific model, they’re also visually striking examples of how advanced computation helps us understand matter in extreme environments. Explore these simulations and see the beauty of physics in motion.

Carbon
ρ = 5.7 g/cc,
T = 8.62 eV
One-component Plasma simulation videos
Learn about the One-component Plasma model.
Un-magnetized OCP:
| Top view: | ||||||||
|---|---|---|---|---|---|---|---|---|
| Γ = 0.1 | Γ = 0.2 | Γ = 1 | Γ = 10 | Γ = 25 | Γ = 50 | Γ = 100 | Γ = 150 | Γ = 175 (bcc) |
| Skewed view: | ||||||||
| Γ = 0.1 | Γ = 0.2 | Γ = 1 | Γ = 10 | Γ = 25 | Γ = 50 | Γ = 100 | Γ = 150 | Γ = 175 (bcc) |
Magnetized OCP:
| Top view (i.e., projected along the magnetic field direction): | ||||||||||
|---|---|---|---|---|---|---|---|---|---|---|
| Γ = 0.1: | β = 0.1 | β = 0.25 | β = 0.5 | β = 1 | β = 2 | β = 5 | β = 10 | β = 50 | β = 100 | |
| Γ = 1: | β = 0.1 | β = 0.25 | β = 0.5 | β = 1 | β = 2 | β = 5 | β = 10 | β = 50 | ||
| Γ = 50: | β = 0.1 | β = 0.25 | β = 0.5 | β = 1 | β = 2 | β = 5 | β = 10 | β = 50 | ||
| Skewed view (the vertical direction is along the magnetic field): | ||||||||||
| Γ = 0.1: | β = 0.1 | β = 0.25 | β = 0.5 | β = 1 | β = 2 | β = 5 | β = 10 | β = 50 | β = 100 | |
| Γ = 1: | β = 0.1 | β = 0.25 | β = 0.5 | β = 1 | β = 2 | β = 5 | β = 10 | β = 50 | ||
| Γ = 50: | β = 0.1 | β = 0.25 | β = 0.5 | β = 1 | β = 2 | β = 5 | β = 10 | β = 50 | ||
Binary Ionic Mixtures videos
- Hydrogen (green) with trace (0.5%) of iron (blue) at Γ = 10.
- Iron (blue) with trace of hydrogen(0.5%) (green) at Γ = 10.
Orbital-free molecular dynamics electron density videos

Meet the Team
Los Alamos brings together experts from diverse backgrounds, including plasma physics, dynamic fluid flows, and computational sciences. Join us to tackle complex challenges in energy research, astrophysics, and inertial confinement fusion.